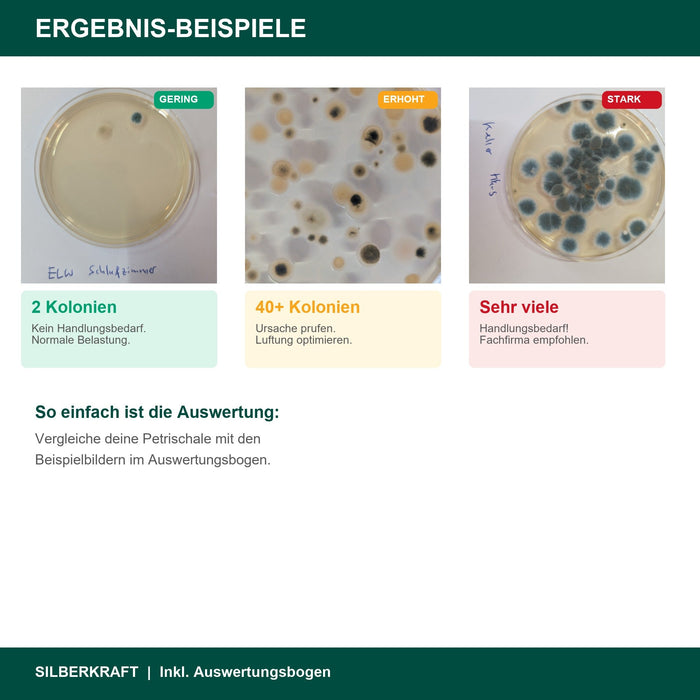
Schimmeltest Ergebnis-Beispiele - Gering Erhoht Stark
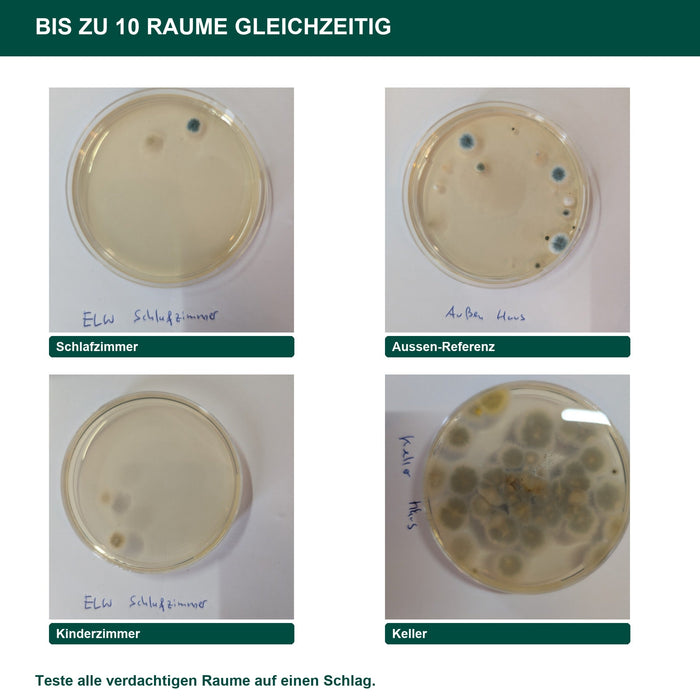
Bis zu 10 Raume gleichzeitig testen mit dem XXL Set
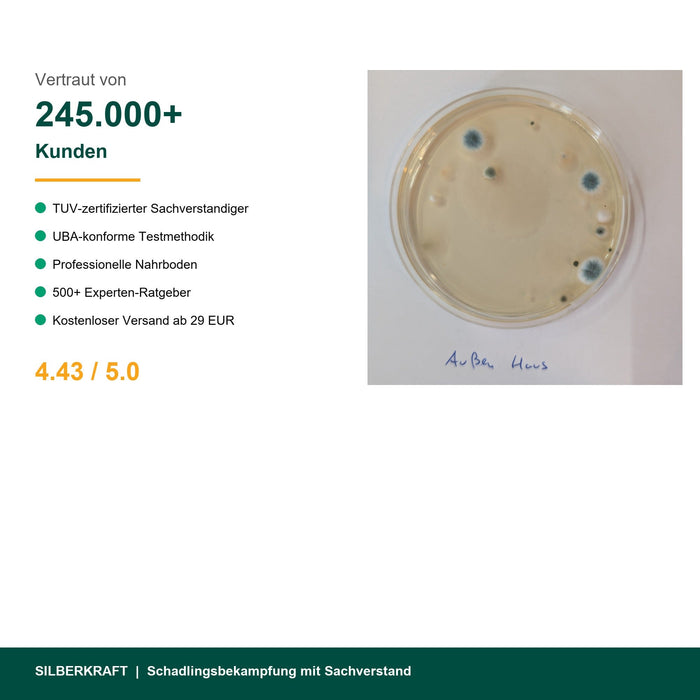
245000 Kunden vertrauen Silberkraft Schimmeltest
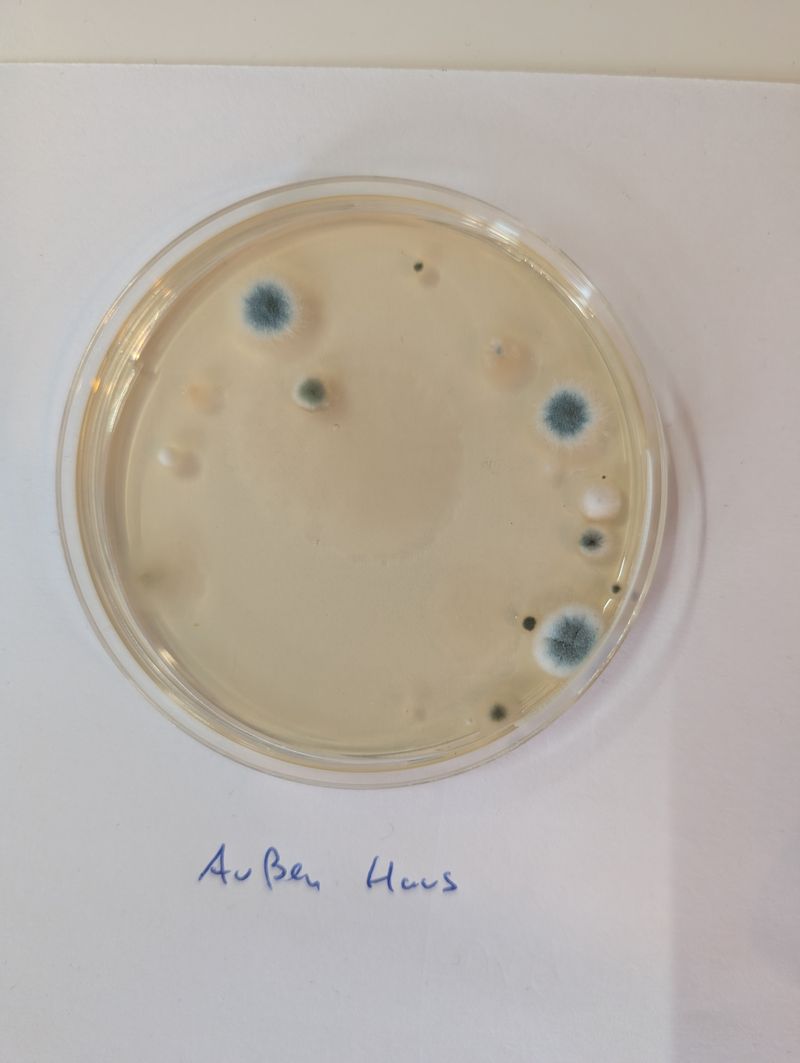
Außenluft (Referenz)
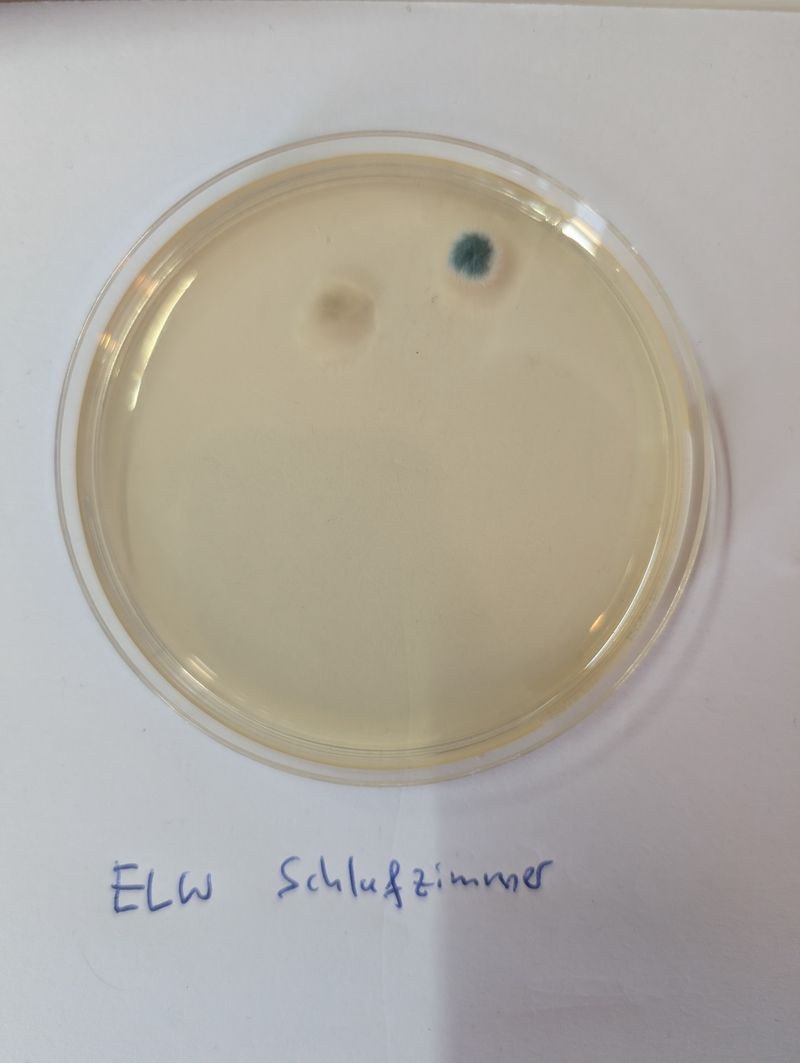
Schlafzimmer (ELW)
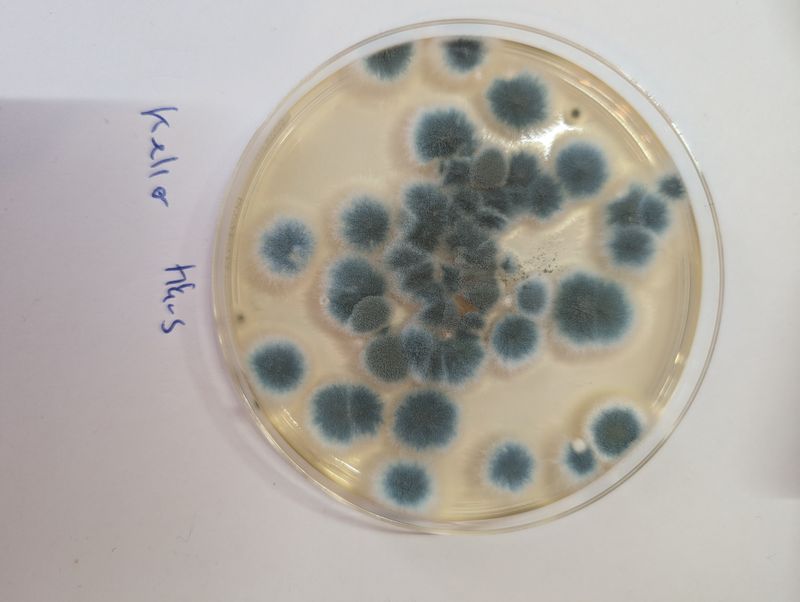
Keller (starker Befall)
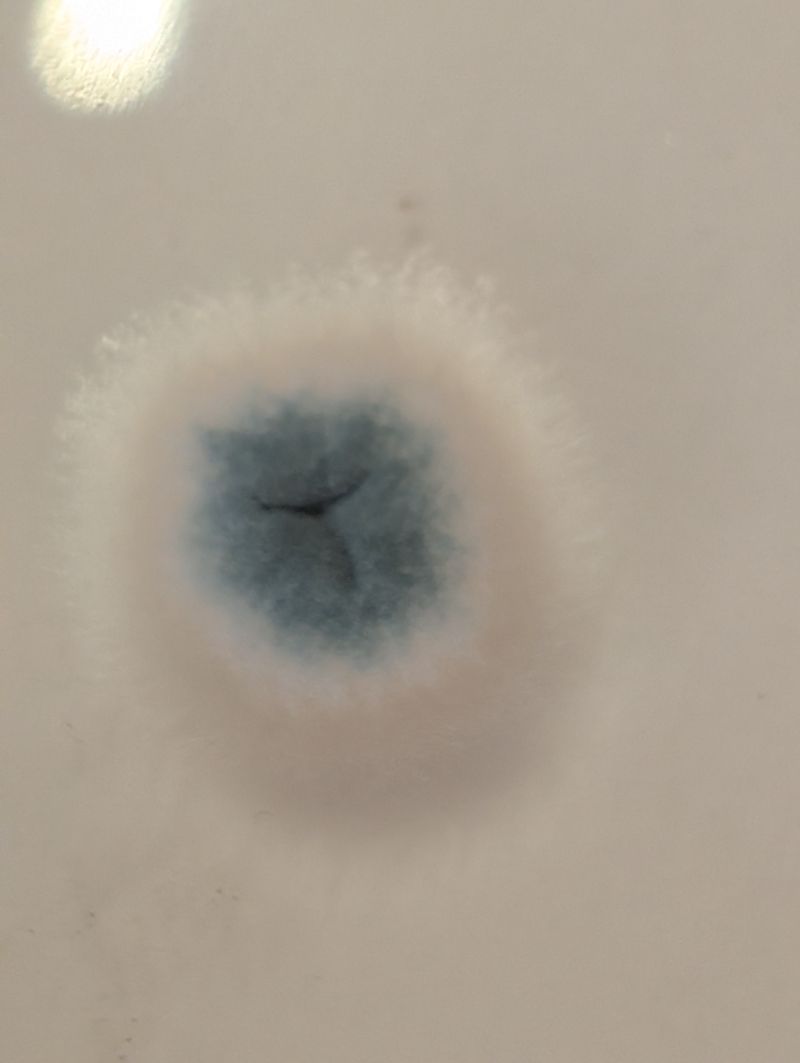
Detailaufnahme Kolonien
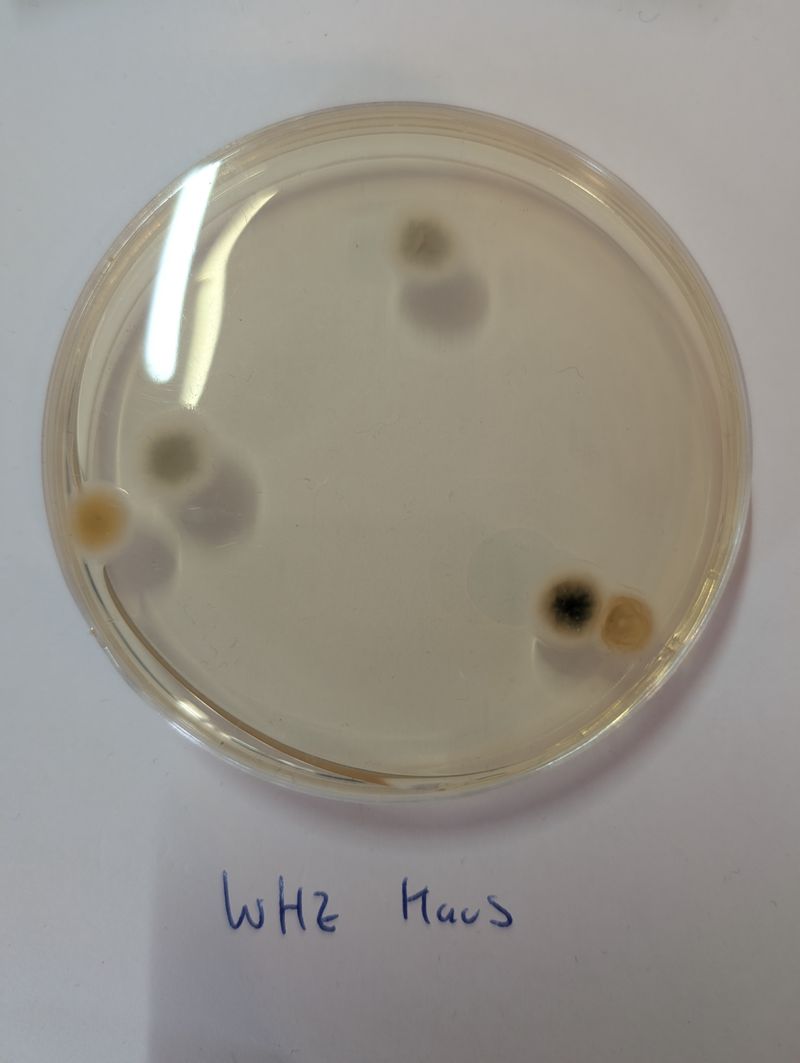
Küche
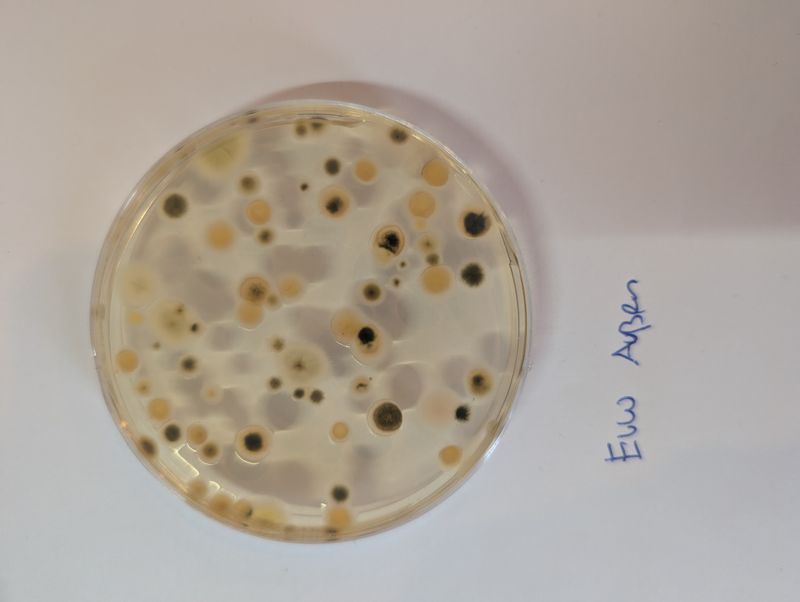
Badezimmer

Schimmeltest Raumluft XXL: Dein zuverlässiger Schimmel Selbsttest für ein gesundes Zuhause
Ein gesundes Zuhause beginnt mit sauberer Luft. Doch oft lauern unsichtbare Gefahren in den Räumen, in denen wir leben: Schimmelsporen. Diese mikroskopisch kleinen Pilzsporen können die Raumluft belasten und ernsthafte gesundheitliche Probleme verursachen. Mit dem Silberkraft Schimmeltest Raumluft XXL erhältst du ein professionelles Testkit, mit dem du Schimmelsporen in der Raumluft schnell, einfach und zuverlässig nachweisen kannst – ganz ohne teure Laboranalyse.
Was ist der Schimmeltest Raumluft XXL und wie funktioniert er?
Der Silberkraft Schimmeltest Raumluft XXL ist ein Schimmelpilz Schnelltest für Zuhause, der auf dem bewährten Sedimentationsverfahren basiert. Das Set enthält 10 hochwertige Petrischalen mit speziellem Nährboden, auf dem Schimmelsporen aus der Raumluft wachsen und sichtbar werden. Anders als bei einem einfachen Schimmeltest ermöglicht dir das XXL-Format die gleichzeitige Untersuchung von bis zu 10 verschiedenen Räumen – ideal für eine umfassende Analyse deines gesamten Wohnbereichs.Die Durchführung ist denkbar einfach: Du stellst die geöffneten Petrischalen für zwei Stunden in den zu testenden Räumen auf. In dieser Zeit sinken die in der Luft schwebenden Schimmelsporen auf den Nährboden ab. Nach einer Inkubationszeit von 7 bis 10 Tagen bilden sich sichtbare Schimmelkolonien, die du mithilfe des beiliegenden Auswertungsbogens einfach selbst analysieren kannst. So erhältst du eine klare Einschätzung der Schimmelbelastung – von "gering" bis "sehr hoch".
Für wen ist der Schimmel Selbsttest besonders geeignet?
Der Schimmeltest Raumluft ist für alle Menschen relevant, die Gewissheit über die Luftqualität in ihren Wohnräumen haben möchten. Besonders empfehlenswert ist er in folgenden Situationen: Altbau-Bewohner und Mieter älterer Gebäude: Altbauten verfügen häufig über unzureichende Dämmung und sogenannte Wärmebrücken – Stellen, an denen Kälte eindringt und Feuchtigkeit kondensiert. Genau hier siedeln sich Schimmelpilze besonders gerne an. Ein regelmäßiger Schimmeltest gibt dir die Sicherheit, dass deine Wohnräume nicht belastet sind.
Familien mit Kindern und Babys: Kinder, insbesondere Säuglinge und Kleinkinder, reagieren besonders empfindlich auf Schimmelsporen. Ihr Immunsystem ist noch nicht vollständig entwickelt, wodurch sie anfälliger für Atemwegserkrankungen und Allergien sind. Ein Schimmeltest schützt die Gesundheit deiner Liebsten.
Allergiker und Asthmatiker: Menschen mit Allergien oder Asthma leiden oft unter einer erhöhten Schimmelbelastung in der Raumluft. Schimmelsporen können Asthmaanfälle auslösen, allergische Reaktionen verstärken und die Atemwege dauerhaft reizen. Mit einem Schimmeltest kannst du potenzielle Auslöser identifizieren und beseitigen.
Personen mit unerklärlichen Gesundheitsbeschwerden: Chronische Kopfschmerzen, anhaltende Müdigkeit, Konzentrationsschwäche, Hautausschläge oder wiederkehrende Atemwegsprobleme können auf eine Schimmelbelastung hindeuten. Viele Betroffene suchen lange nach der Ursache ihrer Symptome – ein Schimmeltest kann hier schnell Klarheit schaffen.
Hausbesitzer und Vermieter: Ob vor dem Verkauf, nach einem Wasserschaden oder zur regelmäßigen Kontrolle – ein Schimmeltest dokumentiert den Zustand der Immobilie und hilft, Schäden frühzeitig zu erkennen, bevor sie zu kostspieligen Sanierungen führen.
Warum ist die Früherkennung von Schimmel so wichtig?
Schimmel in der Wohnung ist nicht nur ein ästhetisches Problem – er stellt eine ernsthafte Gesundheitsgefahr dar. Das Umweltbundesamt warnt eindringlich vor den Risiken von Schimmelpilzen in Innenräumen. Schimmelsporen und deren Stoffwechselprodukte, sogenannte Mykotoxine, können über die Atemluft in den Körper gelangen und dort erheblichen Schaden anrichten.Gesundheitliche Auswirkungen von Schimmel umfassen Atemwegserkrankungen wie chronischen Husten, Bronchitis und Asthma. Schimmelsporen reizen die Schleimhäute und können bei langfristiger Exposition zu dauerhaften Lungenschäden führen. Viele Menschen entwickeln allergische Reaktionen gegen Schimmelpilze, die sich durch Niesanfälle, tränende Augen, Hautausschläge und Atemnot äußern. Besonders gefährlich ist der sogenannte "Schwarze Schimmel" (Aspergillus niger), der bei immungeschwächten Personen schwere Lungeninfektionen auslösen kann.Langfristige Exposition gegenüber Schimmelsporen kann zu chronischer Erschöpfung, Konzentrationsstörungen und einem geschwächten Immunsystem führen. Einige Schimmelpilzarten produzieren Neurotoxine, die Kopfschmerzen, Schwindel und Gedächtnisprobleme verursachen können. Die Weltgesundheitsorganisation (WHO) stuft Schimmel in Innenräumen als erhebliches Gesundheitsrisiko ein. Besonders betroffen sind Risikogruppen wie Kinder, ältere Menschen, Schwangere und Personen mit geschwächtem Immunsystem. Eine frühzeitige Erkennung durch einen Schimmeltest ist daher der erste und wichtigste Schritt zum Schutz deiner Gesundheit.
Welche Vorteile bietet der Silberkraft Schimmeltest Raumluft XXL?
10 Petrischalen für umfassende Analyse: Im Gegensatz zu vielen Konkurrenzprodukten, die nur eine oder wenige Petrischalen enthalten, bietet unser XXL-Set 10 Testmöglichkeiten. Das bedeutet: Du kannst dein gesamtes Zuhause – vom Keller über Bad und Küche bis zu Schlaf- und Kinderzimmern – in einem Durchgang testen. Das spart nicht nur Geld, sondern gibt dir auch ein vollständiges Bild der Situation.Expertenwissen von Philipp – aus der Praxis für die Praxis: Was unseren Schimmeltest wirklich besonders macht, ist das mitgelieferte E-Book von unserem Experten Philipp. Er ist kein theoretischer Schreibtischexperte, sondern hat selbst einen jahrelangen Kampf gegen hartnäckigen Schimmelbefall in seinem Altbau geführt. Philipp hat alle gängigen Methoden ausprobiert – von Hausmitteln über chemische Schimmelentferner bis hin zu baulichen Maßnahmen. In seinem umfassenden Ratgeber teilt er sein gesamtes Wissen mit dir: Wie du die Ursache des Schimmelbefalls findest (Feuchtigkeit, Wärmebrücken, falsches Lüften), welche Sofortmaßnahmen wirklich helfen, wie du Schimmel dauerhaft beseitigst und einem erneuten Befall vorbeugst, wann du einen Fachmann hinzuziehen solltest und welche rechtlichen Aspekte bei Mietwohnungen zu beachten sind.Einfache Selbstauswertung ohne Labor: Während viele Schimmeltests eine teure Laboranalyse erfordern, kannst du unseren Test komplett selbst auswerten. Der detaillierte Auswertungsbogen enthält Referenzbilder verschiedener Belastungsstufen und eine klare Bewertungsskala. Du benötigst keinerlei Vorkenntnisse und sparst dir die Kosten und Wartezeit einer Laboruntersuchung.Made in Germany – Qualität, auf die du dich verlassen kannst: Unser Schimmeltest wird unter strengen Qualitätskontrollen in Deutschland hergestellt. Die Nährböden sind optimal auf die Anzucht von Schimmelpilzen abgestimmt und liefern zuverlässige Ergebnisse.
Wo solltest du den Schimmeltest durchführen?
Schimmel kann überall dort entstehen, wo Feuchtigkeit auf organisches Material trifft. Besonders gefährdet sind Badezimmer, in denen durch Duschen und Baden viel Wasserdampf entsteht, der sich an kalten Wänden niederschlägt. Schimmel siedelt sich gerne in Fugen, hinter Möbeln und an der Decke an. In der Küche entsteht beim Kochen Feuchtigkeit, die oft nicht ausreichend abgelüftet wird. Bereiche hinter dem Kühlschrank oder unter der Spüle sind besonders anfällig. Im Schlafzimmer reichert sich durch nächtliches Schwitzen und Atmen Feuchtigkeit in der Luft an. Kalte Außenwände und Fensterlaibungen sind Risikozonen. Keller mit feuchten Wänden, mangelnder Belüftung und kühlen Temperaturen schaffen ideale Bedingungen für Schimmelwachstum. Auch auf dem Dachboden können undichte Dächer oder unzureichende Dämmung zu Feuchtigkeitsproblemen führen. Stellen hinter Möbeln und in Ecken, an denen die Luft nicht zirkulieren kann, sind ebenfalls besonders gefährdet.
Mit welchen Silberkraft Produkten lässt sich der Test kombinieren?
Nach einem positiven Testergebnis bietet dir Silberkraft ein komplettes Sortiment zur Schimmelbekämpfung. Der Silberkraft Schimmelentferner ist ein hochwirksames Mittel zur Beseitigung von sichtbarem Schimmelbefall auf Wänden, Fliesen, Fugen und anderen Oberflächen. Die Formel dringt tief in das Material ein und tötet Schimmelsporen zuverlässig ab. Das Silberkraft Anti-Schimmel-Spray ist ideal zur Vorbeugung an gefährdeten Stellen. Das Spray bildet einen Schutzfilm, der das Wachstum von Schimmelpilzen verhindert – perfekt für Bad, Küche und Keller. Die Silberkraft Schimmelstop-Farbe ist eine spezielle Anti-Schimmel-Farbe für Wände und Decken, die einen langfristigen Schutz bietet. Sie enthält fungizide Wirkstoffe, die einen erneuten Befall verhindern.
Fazit: Schütze deine Gesundheit mit dem Schimmeltest Raumluft XXL
Schimmel in der Wohnung ist mehr als nur ein optisches Problem – er ist eine unsichtbare Gefahr für deine Gesundheit und die deiner Familie. Mit dem Silberkraft Schimmeltest Raumluft XXL erhältst du ein professionelles Werkzeug zur Früherkennung, kombiniert mit dem wertvollen Praxiswissen unseres Experten Philipp.Warte nicht, bis aus einem Verdacht ein gesundheitliches Problem wird. Handle jetzt und schaffe Gewissheit! Mit 10 Petrischalen, einem detaillierten Auswertungsbogen und einem umfassenden E-Book-Ratgeber bist du bestens ausgestattet, um Schimmel zu erkennen, zu beseitigen und dauerhaft vorzubeugen.Dein Zuhause soll ein Ort der Gesundheit und des Wohlbefindens sein – mach den ersten Schritt zu einem schimmelfreien Leben!